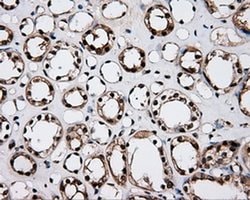
LTA4H Mouse anti-Human, Clone: OTI6B5, liquid, TrueMAB 100 &mu;L | Buy Online | Origene Technologies | Fisher Scientific

missing translation for 'onlineSavingsMsg'
Learn More
Learn More
LTA4H Mouse anti-Human, Clone: OTI6B5, liquid, TrueMAB™

Descripción
Hydrolyzes an epoxide moiety of leukotriene A4 (LTA-4) to form leukotriene B4 (LTB-4). The enzyme also has some peptidase activity.
Especificaciones
Especificaciones
| Antígeno | LTA4H |
| Aplicaciones | Flow Cytometry, Immunohistochemistry (Paraffin), Immunoprecipitation, Western Blot |
| Clasificación | Monoclonal |
| Clon | OTI6B5 |
| Concentración | 0.75 mg/mL |
| Conjugado | Unconjugated |
| Formulación | PBS with 1% BSA, 50% glycerol and 0.02% sodium azide |
| génica | LTA4H |
| N.º de referencia del gen | P09960 |
| Alias de gen | leukotriene A4 hydrolase |
| Mostrar más |
Título del producto
Al hacer clic en Enviar, acepta que Fisher Scientific se ponga en contacto con usted en relación con los comentarios que ha proporcionado en este formulario. No compartiremos su información para ningún otro fin. Toda la información de contacto proporcionada se mantendrá de acuerdo con nuestra Política de Privacidad. Política de privacidad.
¿Detecta una oportunidad de mejora?